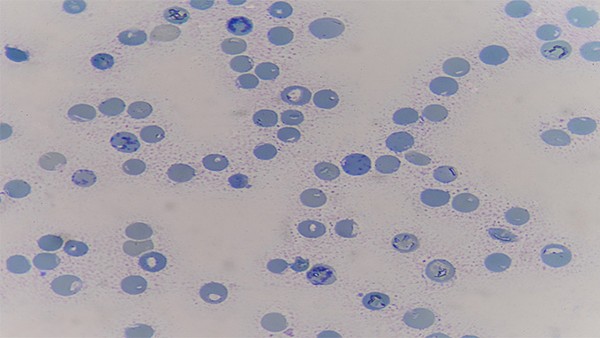

中医是疫情防控“中国计划”不可或缺、不可替代的重要组成部分。12月10日,国家中医药管理局中医疾病防治专家委员会发布了《新冠肺炎感染者家庭中医干预指引》(以下简称《指引》),列出了新冠肺炎的防治方案。

在预防方面,本指南推荐的药物干预有两种,一种是代茶:生黄芪9g、金银花5g、广藿香3g。每天一剂,开水泡,代茶频繁饮用。适合普通人的预防。二是玉屏风颗粒:每次5克,一天三次。适合容易体虚感冒、自汗恶风的人。
在治疗方面,本指南分别列出了成人和儿童的治疗方案。
在成人治疗方案中,如发热、恶风寒、肌肉酸痛、咽干咽痛、乏力、鼻塞流鼻涕或咳嗽,应服用具有疏风解毒作用的中成药,如疏风解毒胶囊(颗粒)、清肺排毒颗粒、散寒化湿颗粒、感冒清热胶囊(颗粒)、荆防颗粒、正柴胡饮颗粒、九味羌活丸(颗粒)、四季感冒片、感冒疏风胶囊(片、颗粒)等。
再比如咽痛明显、发热、肌肉酸痛、乏力、咳嗽者,应服用具有疏风清热、化湿解表、清热解毒功效的中成药,如连花清瘟胶囊(颗粒)、金花清感颗粒、化湿败毒颗粒、宣肺败毒颗粒、热炎宁合剂、银黄清肺胶囊、连花清咳片、六神丸(胶囊)、银翘解毒颗粒、金叶败毒颗粒、蓝芩口服液、复方秦兰口服液、清咽滴丸、喉咽清颗粒、桑菊感冒片、夏桑菊颗粒、痰热清胶囊、双黄连口服液、柴芩清宁胶囊、抗病毒口服液、感冒退热颗粒、消炎退热颗粒、清开灵颗粒、小柴胡颗粒等。
展开剩余34%
在儿童治疗方案中,如感冒发烧、肌肉酸痛,可使用柴桂退热颗粒、儿童风热清口服液等。另一个例子是发烧、咽干咽痛、咳嗽,可使用金振口服液、儿童肺口服液、儿童咳嗽口服液积累、儿童痰等。
根据指南,上述中成药中的一种是根据说明书剂量服用的,一般为3~如果症状没有缓解或加重,请及时到正规医疗机构就诊。
“考虑到儿童体质特殊,病情变化迅速,应在医生的指导下服用。如果病情发生变化,应及时就医。”该指南称,建议在医生的指导下服用婴儿、哺乳期妇女、孕妇、老年人和合并基础疾病的特殊群体。地方医疗机构可以利用“互联网+医疗”开展家庭健康指导、健康教育、药物咨询等服务,指导群众合理使用中医。